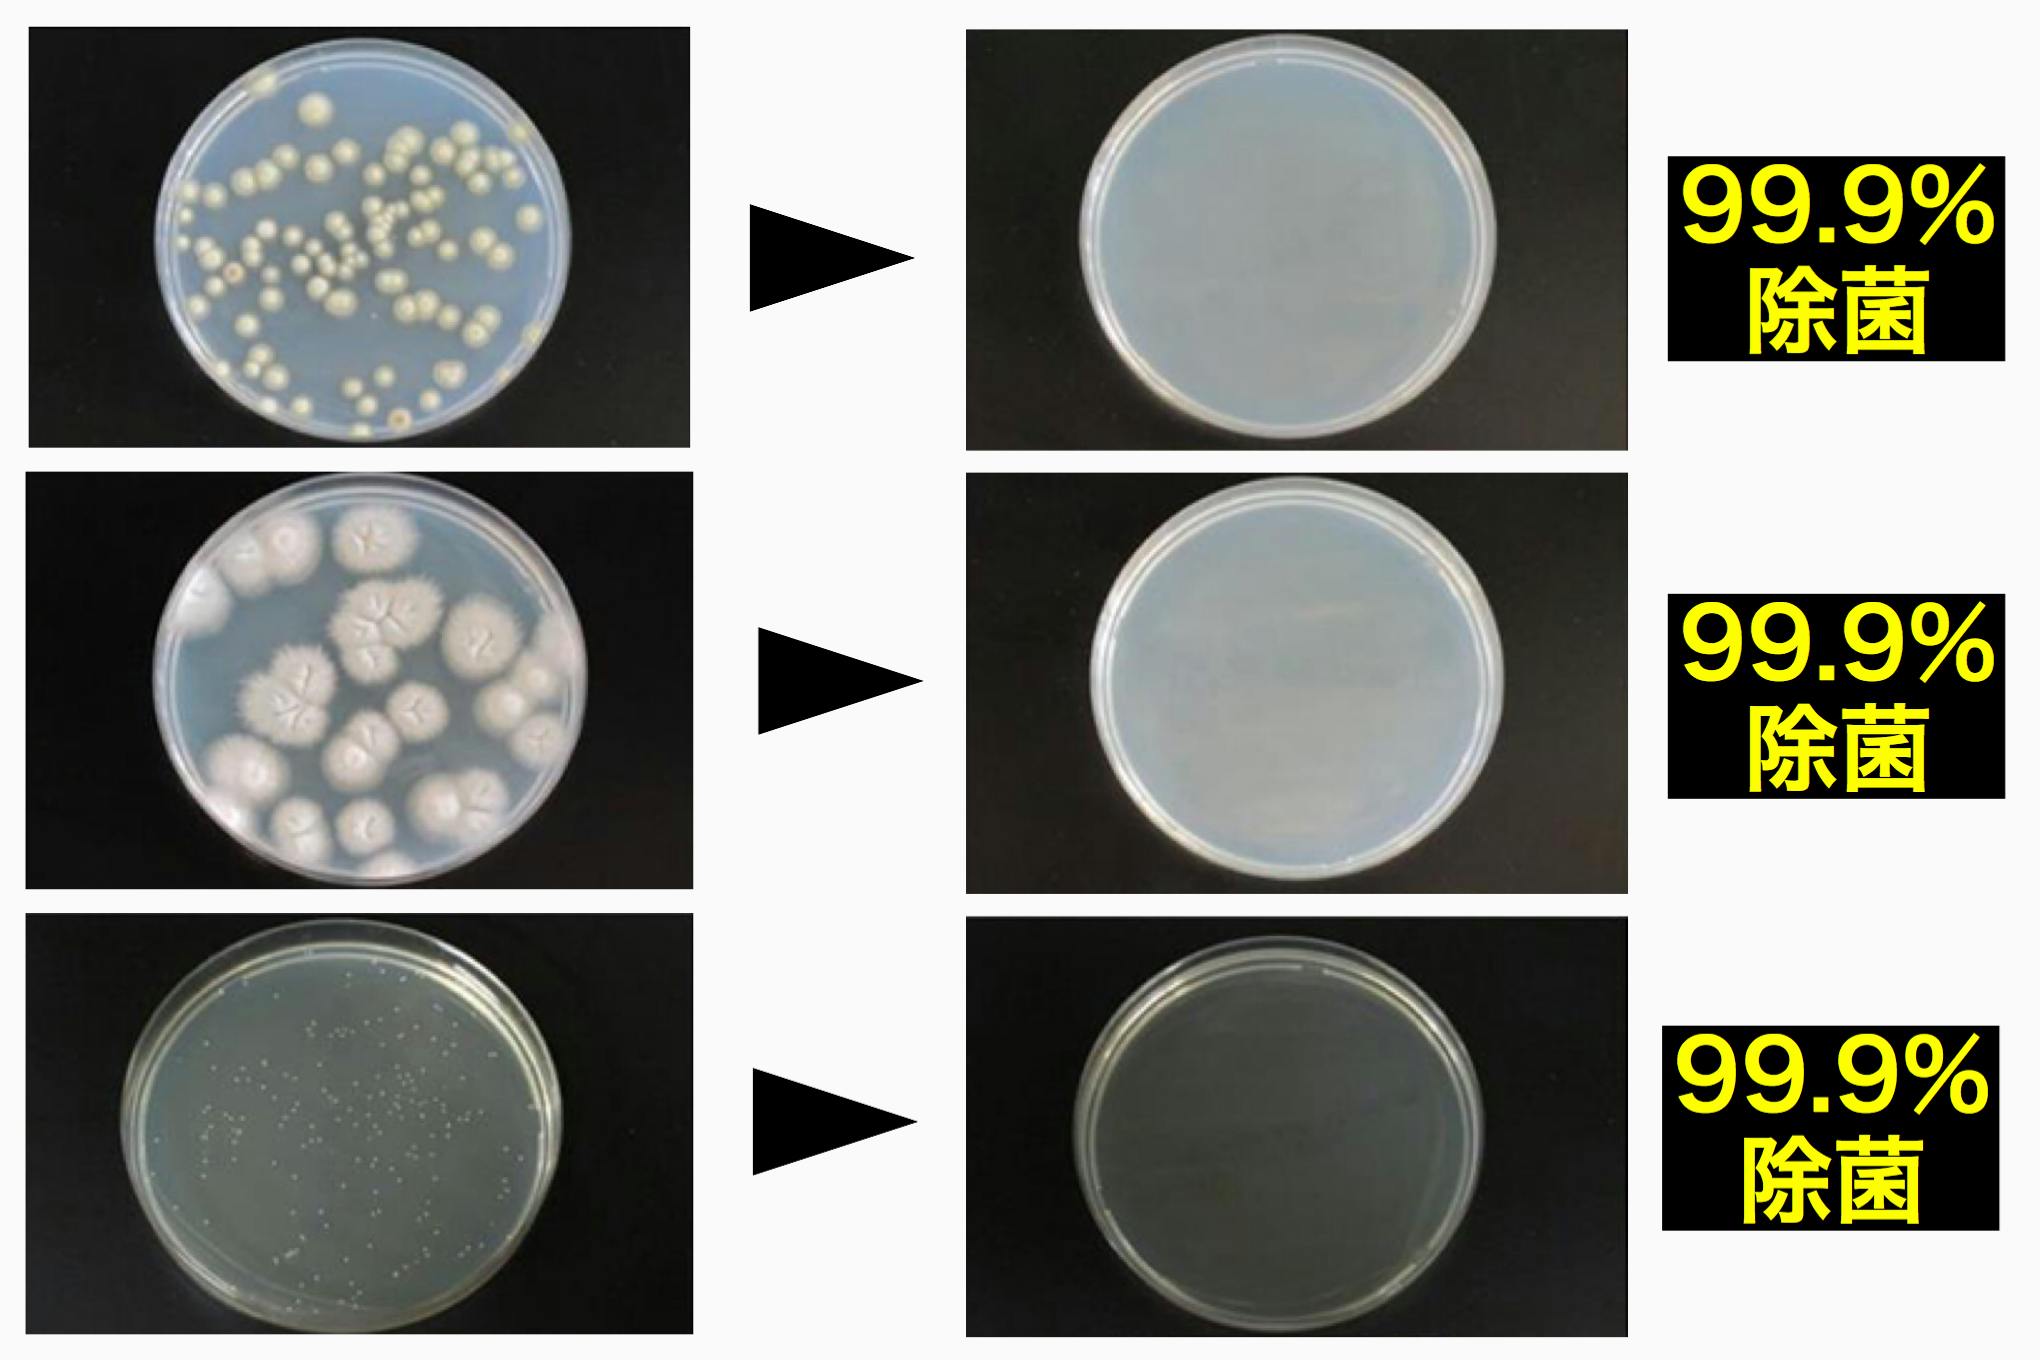

「小物を99.9%除菌できる」UV除菌ボックスを紹介します!
日常生活に欠かすことのできないスマホですが便器の10倍も汚いことをご存知ですか?
Q.なぜこんなに汚いの?
A.様々な場所に触れた手で使用することが原因と考えられています。
さらに雑菌が最も繁殖しやすい温度が30°~40°と言われているのですが、
充電している最中やポッケットに入れている間はちょうどそのくらいの温度になってしまいます。
また、手に付着している水分や皮脂などが雑菌の栄養になってしまいます。
そんなスマホを手軽に除菌して清潔に保つことができるのがこのUV除菌ボックス!

UV除菌ボックスの3つの特徴
①強力UVにより雑菌だけでなく「細菌」や「ウイルス」などにも効果抜群!
②スマホだけでなく「マスク」や「腕時計」などの小物も除菌できる!
スマホだけでなく下の画像のような除菌ボックスに入るサイズの小物なら何でも除菌できます!
水洗いの難しい物でも丸洗いできてしまいます!
使い捨てマスクを繰り返し使うのに抵抗がある方も除菌ボックスで丸洗いできます!

③高速ワイヤレス充電機能を搭載しているので充電器としても使用できる!
フタ部分にワイヤレス充電機能を搭載しているので使用しないときはワイヤレス充電器として使用できます!
10Wのハイパワー仕様なので通常の充電よりも早い急速充電をすることができます!
ワンタッチでカンタン除菌!
除菌したいものを入れてスイッチを押すだけで強力UVを照射して除菌することができます!
医療現場でも使われる強力UVで99.9%除菌!
医療現場でも使われる強力UVにより雑菌だけでなく細菌やウイルスも除菌することができます!
フタを閉じないと動作しない仕組みなのでどなたでも安全に使用できます!

2つの除菌モード!
通常モード(30分)と高速モード(18分)を搭載しているので時間がないときでもササッと除菌することができます。
※高速モードでも効果はありますが99.9%除菌するには通常モードをご利用ください。
使用手順
①除菌したいものをボックスに入れる。
②スイッチを押して待つ。
たったこれだけで99.9%除菌することができます!
専門機関による除菌効果試験済み!
専門機関での試験により99.9%除菌することを証明済みです。
(証明書は転用防止のためにぼかし加工を行なっております。支援者の方で閲覧希望の方がいらっしゃいましたら備考欄よりご連絡ください。)

こだわりポイント
シンプルで清潔感のある洗練されたデザイン


UVが隅々まで届くように計算し尽くして配置した紫外線LED

身の回りの小物も収まる程よいサイズ感
こんな方におすすめ!
・スマホを家の外でも使う方
・不特定多数の人が集まる場所に行く方
・トイレでスマホを使う方
・小さいお子さんやペットがいる方
・身の回りのものを常にきれいにしておきたい方
・アクセサリーや化粧道具を清潔に保ちたい方
製品情報
本体寸法:210*120*62mm
ボックス内部寸法:192*102*31mm
重量:約440g
ワイヤレス充電出力:10W
ワイヤレス充電伝送距離:6mm以内
UV波長:253.7nm
UV出力:2W
紫外線LED:6uvc
本体給電ポート:USB-C
注意
※デザインや仕様が一部変更となる場合がございます。
※予想を上回るご支援をいただけた場合は配送作業に遅れが生じる可能性がございます。
※一般販売価格は変更となる場合がございます。





コメント
もっと見る